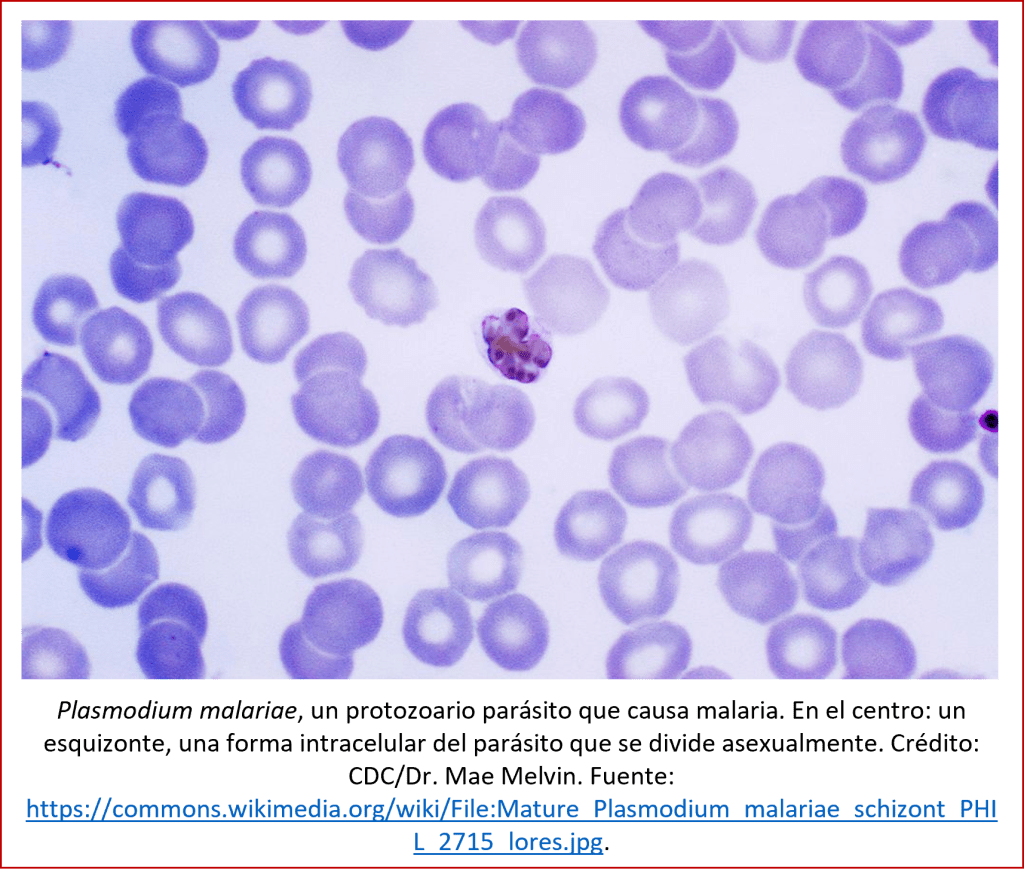

En esta serie de entradas sobre la evolución reciente, no podemos dejar de considerar la especie que, al fin y al cabo, más nos interesa: la nuestra. Si la evolución sigue en acción para las especies en nuestro entorno, ¿no afectaría también a nosotros?
¡Claro que nos afecta! Los humanos estamos expuestos a influencias externas que pueden causar cambios en nuestro acervo genético y por ende, hacer que continúe nuestra evolución. En gran medida nuestra evolución es cultural (ver la entrada de 24 septiembre 2017), o sea, somos capaces de adaptarnos a condiciones nuevas cambiando nuestras conductas y tradiciones, y nuestras tecnologías, pero sin lugar a duda estamos experimentando una continua evolución biológica también.
A pesar de ser la nuestra una de las especies más exitosas en el planeta, esto no debe permitirnos que bajemos la guardia: muchos son los peligros que estamos enfrentando, desde una reducida tasa de natalidad hasta el impacto de virus de distintas índoles y la degradación de nuestro medio ambiente. Inclusive hay quienes auguran que como especie llevamos todas las de estar enrumbados hacia una extinción segura [1].
Puesto que ya nos dedicamos a la evolución reciente del género humano en una entrada anterior (la del 14 enero 2018), nos dedicaremos en la presente entrada a unos aspectos específicos de nuestra evolución actual.
Por qué sigue la evolución humana
Es lícito preguntarnos si la humanidad, con lo desarrollada que es nuestra tecnología y nuestra ciencia médica, sigue experimentando evolución biológica, de la misma manera que la experimentaban nuestros lejanos antepasados. Al fin y al cabo, la evolución depende de la supervivencia de los individuos mejor adaptados, y hoy en día somos capaces de hacer que tanto los mejor adaptados como los menos adaptados puedan tener descendientes y así pasar sus genes – buenos o malos, sin distinción – a la siguiente generación. ¿O no?
Veamos primero la teoría. El principal mecanismo mediante el cual se da la evolución, es la selección natural. Este mecanismo fue identificado por el naturalista inglés Charles Darwin (1809-1882) [2], quien formuló en su principal obra, El origen de las especies [3], las bases científicas del proceso de evolución de los organismos vivientes (ver la entrada de 26 octubre 2014). Darwin basó su hipótesis en cuatro observaciones [4]. En primer lugar, planteó que, tanto en el reino animal como el vegetal, los descendientes se parecen a sus padres. En segundo y tercer lugar afirmó que, a pesar de eso, existen diferencias entre padres e hijos, resultando en individuos con características distintas, y que el número de descendientes es más grande de lo necesario para que se mantenga la especie. Y por último sostuvo que, al tener límites el tamaño que puede tener la población de una especie, por ejemplo debido a la disponibilidad de alimentos, hay en la naturaleza una lucha por la supervivencia (struggle for existence), que hará que aquellos con las características más adecuadas tengan más probabilidad de sobrevivir y procrearse (lo que posteriormente se llamó survival of the fittest).
De eso, Darwin sacó la conclusión siguiente: si nace un ejemplar de una especie, con alguna característica diferente que le pone en condiciones para sobrevivir con más facilidad que los otros individuos de la misma especie, y engendrar más descendientes de los cuales por lo menos algunos tendrán la misma característica, este ejemplar puede ser el inicio de una nueva variedad de la especie, que eventualmente puede desplazar y reemplazar los individuos menos adaptados. Este proceso de selección natural, afirmó Darwin, es la causa de los cambios continuos de las especies.
Por otro lado, si nace un ejemplar con algún defecto, que le pone en desventaja frente a los demás individuos de la población, es probable que vaya a tener menos descendientes, o más probablemente, ninguno, de manera que el defecto no se mantendrá en la población.
¿Qué de todo esto aplica a los humanos de hoy en día? En los países desarrollados, donde la atención médica es buena y hay alimentos para todos, prácticamente no existe – por lo menos en el sentido biológico – ninguna lucha por la supervivencia. Pero en otras regiones, donde las condiciones son más extremas (por ejemplo, en la alta montaña, o las selvas tropicales), sí puede tener mucha relevancia con cuáles variantes genéticas nace un niño o una niña. También es importante el acervo genético en países donde hay enfermedades que aun no tienen cura, o donde la población no tiene acceso a esta. En tales condiciones, la selección natural puede actuar, y en efecto lo hace, causando una evolución continua de nuestra especie. Es así que hubo poblaciones humanas que lograron adaptarse a la vida en la alta montaña, a una dieta a base de lácteos, o a la convivencia con la malaria.
Además de esto, cabe destacar que también ocurren procesos evolutivos que no están relacionados con la selección natural. Por ejemplo, cuando el cuerpo humano masculino elabora espermatozoides, se recompone el material genético de estos; en este proceso, se utilizan preferencialmente las bases C y G del código genético, en detrimento de las bases A y T. Esto causa mutaciones genéticas no relacionadas a selección natural, y que han causado cambios relativamente grandes en ciertos genes humanos [5]. Mientras que se estén dando estos cambios genéticos, independientes de la selección natural, continuará la evolución humana.
Otro mecanismo de cambios genéticos que no están relacionados a la selección natural, es lo que se llama genetic drift, o sea, la deriva genética. Se trata de cambios genéticos aleatorios, que – especialmente en el caso de una población pequeña – pueden causar cambios evolutivos [6]. Sin embargo, este proceso no parece jugar un papel importante en la evolución humana actual: de varios rasgos complejos (tales como la estatura, la relación cintura-cadera, y la incidencia de esquizofrenia), que son distintos en poblaciones humanas distintas, se pudo determinar mediante un estudio genético que las variaciones entre grupos se deben a procesos de selección natural, no a los procesos aleatorios característicos de la deriva genética [7].
Las enfermedades
Una fuerza poderosa que causa cambios en el genoma humano, es la ejercida por las enfermedades. Si una enfermedad afecta a una población y causa muchas muertes, y hay un individuo que tiene alguna mutación genética que confiere cierta resistencia contra esta enfermedad, este individuo tendrá buenas posibilidades de sobrevivir a la enfermedad y de pasar su mutación genética a sus descendientes. Algunos de estos descendientes probablemente tendrán la mutación también, mientras que los individuos de la población que no la tienen, correrán el riesgo de caer enfermos y morir sin haber dejado descendientes. De esta manera, la mutación beneficiosa se volverá más común en la población, a lo largo de unas pocas generaciones. Es de esta manera que las enfermedades causan cambios evolutivos.
Esto ha ocurrido múltiples veces en la historia humana y, tal como estamos viendo, sigue ocurriendo: un patógeno nuevo (por ejemplo, un virus que anteriormente estaba viviendo en algún animal) infecta a un humano, cuyo cuerpo no conoce el virus y por ende no tiene defensas para combatirlo, dando origen a una ola de contagios. Ejemplos de esto, en los últimos miles de años, son la aparición de la peste (ver también la entrada de 16 abril 2018), o las enfermedades que los conquistadores españoles llevaron a América y que causaron una gran mortalidad entre los pueblos autóctonos [8].
La malaria es una enfermedad antigua, pero que todavía afecta a muchas personas: aproximadamente doscientos millones a nivel mundial, causando unas 400.000 muertes anuales. Es causada por un parásito unicelular llamado Plasmodium (ver imagen), que entra en el cuerpo humano mediante la picadura de un mosquito, Anopheles [9]. El impacto de la malaria sobre la población humana en grandes partes de África ha sido tal que han surgido mutaciones genéticas que aumentan la resistencia contra esta enfermedad. La ventaja de tener una de estas mutaciones es tan grande que el porcentaje de portadores de estas mutaciones en una población aumenta rápidamente, dando origen a un cambio evolutivo a nivel genético. Por ejemplo, una variante genética en el receptor de antígenos DARC, la cual proporciona resistencia a la malaria y que es muy común en África occidental, fue introducida hace unas veinte generaciones en las islas de Cabo Verde y ya se convirtió, por lo menos en la isla de Santiago, en la variante más común del receptor DARC. Veinte generaciones son pocas para un cambio tan importante, lo que demuestra la gran ventaja de tener esa mutación [10].
Sin embargo, la resistencia a la malaria (y, en general, a alguna enfermedad infecciosa) tiene un precio. En muchos casos de resistencia, esta se debe a una reacción inflamatoria más fuerte del cuerpo del enfermo: la inflamación es la principal arma que tiene el cuerpo para combatir los patógenos, de manera que una inflamación intensa proporciona mejores probabilidades de vencerle al patógeno. Pero inflamaciones son un arma de doble filo: también pueden causar otras enfermedades, tales como lupus, la enfermedad de Crohn, o la enfermedad intestinal inflamatoria. De la misma manera, personas con mucho material genético proveniente de los neandertales (los “primos” de nuestra especie, ahora desaparecidos), tienen mayor resistencia a infecciones del HIV-1 (el virus del SIDA) y de estafilococos, pero a costa de tener una mayor propensión a desarrollar alergias. En términos generales, los patógenos encontrados por los humanos durante sus migraciones por el planeta han causado adaptaciones evolutivas rápidas, que a menudo vinieron con ciertas desventajas [11] – que probablemente causarán a su vez cambios evolutivos en las poblaciones humanas afectadas.
Esto nos conduce al campo de la coevolución. A menudo, cuando un patógeno causa cambios evolutivos en los humanos, el patógeno experimenta modificaciones también. Comúnmente, un patógeno, que inicialmente causó una alta mortandad entre los humanos que infectó, se vuelve más benigno con el tiempo: mantiene con vida a los humanos contagiados , de manera que el patógeno tenga mayores probabilidades de multiplicarse en el cuerpo humano y salir del mismo, contagiando a otras personas. Este proceso, descrito en la entrada de 19 diciembre 2020 para el virus que causa el COVID-19, ha sido observado en varias enfermedades infecciosas, tales como la lepra (ver imagen), la tuberculosis (ver imagen), y la treponematosis: inicialmente eran mortales, pero paulatinamente se volvieron más leves, dejando los pacientes con vida durante mucho tiempo [12]. Mientras que la treponematosis era común en América antes de la llegada de los europeos, la tuberculosis ha sido una de las enfermedades que más muertes causó en Europa y otros continentes: unas mil millones de muertes durante los últimos dos mil años (después de un período de mortalidad variable) [13].
Cambios fisiológicos: a veces más, a veces menos
En la entrada de 14 enero 2018 ya hablamos de algunos cambios recientes que experimentaron nuestros cuerpos, tales como el aumento del volumen cerebral (probablemente debido en primer lugar a una intensificación de la vida social [14]), la aparición de ojos azules hace poco más de seis mil años, y el aumento de la estatura en ciertas poblaciones. Pero cabe destacar también la desaparición de ciertos rasgos. Nuestros antepasados eran, por ejemplo, capaces de mover las orejas, pero nosotros ya no – por lo menos, la mayoría de nosotros. Mientras que otros mamíferos, como los perros y los gatos, mueven sus orejas ágilmente gracias a un grupo de músculos específicos, llamados auriculares, los humanos ya no necesitamos esta capacidad, y los auriculares se atrofieron (ver imagen). Pero algunos todavía tienen vestigios de este grupo de músculos, y por tanto son capaces de mover, aunque fuera un poco, las orejas. Esta capacidad no afecta nuestra adaptación, así que no ha desaparecido por completo, aunque tampoco conlleve una ventaja evolutiva [15].
El ambiente
Nuestro entorno nos influye, y nos puede hacer cambiar. Especialmente aquellos humanos que se fueron a vivir en ambientes extremos, experimentaron cambios que dieron origen a un proceso evolutivo.
Un buen ejemplo de evolución en un ambiente extremo, es la adaptación humana a una vida en la alta montaña. A elevaciones superiores a unos 2500m, la presión atmosférica y por ende la densidad del aire es significativamente menor que cerca del nivel del mar, lo que implica que la cantidad de oxígeno es más baja. Las personas que viven a tales alturas requieren de cuerpos capaces de funcionar bien a pesar de esta hipoxia. Se ha realizado estudios de indios quechua, que viven en los Andes peruanos (ver la portada de esta entrada), y se encontró que estas personas tienen pulmones más grandes, más hemoglobina (el compuesto que transporta el oxígeno) en la sangre, y una mayor capacidad aeróbica. Estas características están asociadas a variantes genéticas, comunes entre los quechua pero raras en poblaciones de áreas bajas. Por ejemplo, se ha identificado una variante del gen EGLN1, que les proporciona a las células una mejor capacidad de funcionar en entornos con niveles bajos de oxígeno [16]. Una variante en este gen fue detectado también en los tibetanos, que viven a alturas de alrededor de 4000 metros [17] (ver la entrada de 14 enero 2018). Las variantes genéticas de los quechua aparecieron hace unos 8500 años [18], presumiblemente cuando se poblaron por vez primera los Andes peruanos. Aparte de cambios genéticos, también se dieron cambios epigenéticos, es decir, modificaciones de la activación de genes [19].
Cambios en el ambiente obligaban a los humanos a ajustar sus hábitos, mostrando como la adaptabilidad de nuestra especie ha permitido a nuestros ancestros sobrevivir en entornos desfavorables y/o cambiantes. Estudios arqueológicos llevados a cabo en la Patagonia Chilena, una región inhóspita, con glaciares y escasa vegetación, mostraron cómo los pobladores entre 6500 y 2500 años antes de Cristo dependían mucho de pescados tales como el bacalao austral (Salilota australis) [20], mientras que después, cuando hubo una época de derretimiento de los glaciares, los pescados disponibles en la región cambiaron y los pobladores tuvieron que cambiar su dieta [21].
La alimentación
Nuestra manera de alimentarnos es en parte un rasgo cultural. Dependiendo de las técnicas que utilizamos para procurar alimentos y de la importancia que les damos a las distintas opciones de alimentación que tenemos, nuestras dietas tienen sus propias características. En algunos casos, nuestros cuerpos han tenido que adaptarse a estas dietas: o sea, se dio evolución biológica en función de aspectos culturales. El ejemplo mejor conocido de este fenómeno, es el consumo de la leche. Tal como vimos en la entrada de 14 octubre 2017, los humanos somos únicos entre los mamíferos en que los adultos de muchas poblaciones humanas (pero ciertamente no todas) somos capaces de digerir la leche. En distintas poblaciones del mundo que se dedican al pastoreo (que es un rasgo cultural), se ha desarrollado la capacidad de procesar la lactosa (evolución biológica), lo que permite también a los adultos aprovechar esa fuente rica en energía y nutrientes que es la leche. Esto hizo posible muchas cosas: entre otras cosas, es probable que la expansión de los pueblos de las estepas al norte del Mar Negro y el Caspio, que al inicio de la Edad del Bronce (hace unos cinco mil años) llevaron a Europa su tecnología, su idioma indoeuropeo y sus genes, pudo darse gracias al consumo de productos lácteos [22].
De un punto de vista genético, lo que les pasó a las personas adultas que ostentan tolerancia a la lactosa, es que su material genético contiene alguna mutación en el gen que es responsable de la regulación de la elaboración de la lactasa (la enzima que permite la digestión de la lactosa), de manera que no funciona el interruptor genético que debería apagar la producción de lactasa al término de la infancia. Este interruptor se mantiene en posición de “encendido”. En Europa, la variante que más impacto tiene sobre la persistencia de la lactasa se llama rs4988235-A; está ubicado en el gen TLR6, asociado con la respuesta inmunológica a patógenos; esta variante apareció hace tan solo unos tres mil años [23]. En otras poblaciones con alta tolerancia a la lactosa, tales como los Fulani en África centro-oriental, las mutaciones responsables son distintas [24].
Cambios recientes en los alimentos sólidos están impactando nuestras dentaduras. Durante el último siglo, la dieta en muchas poblaciones ha cambiado: en lugar de consumir importantes cantidades de alimentos fibrosos que requieren masticar mucho, muchas personas se criaron comiendo alimentos blandos que no requieren de mucha actividad de las muelas. Como consecuencia, las mandíbulas se han vuelto más cortas y hay menos espacio para nuestros dientes. Por ende, las muelas del juicio suelen salir mal en la mayoría de personas en los países desarrollados, al no tener suficiente espacio para desarrollarse. Esto es otro ejemplo de cambios biológicos como consecuencia de cambios culturales (aunque el acortamiento de las mandíbulas no necesariamente va a convertirse en un cambio evolutivo: si las nuevas generaciones volverán a consumir alimentos que requieren mucho masticar, sus mandíbulas podrían volver a tener sus dimensiones originales) [25].
La alimentación ha sido considerada también como causante del aumento en estatura que varias poblaciones a nivel mundial, pero especialmente en Europa, han experimentado (ver imagen). Tal como ya se describió en la entrada de 14 enero 2018, en países como los Países Bajos la estatura promedio ha aumentado considerablemente durante las últimas generaciones. Sin embargo, este aumento de estatura parece tener una causa más genética que nutricional: se ha descrito rasgos genéticos que, en gran medida, pueden explicar el aumento en la estatura de los europeos del norte desde tiempos prehistóricos, debido especialmente a un aumento de la longitud de las piernas. O sea, el aumento de estatura, aunque puede estar influido por una mejora en la alimentación, se debe en buena parte a la aparición de nuevas variantes genéticas [26].
El estilo de vida
Nuestro estilo de vida, o sea, nuestras actividades, tienen consecuencias evolutivas también. Los bajau por ejemplo, conocidos como los nómadas del mar, son un pueblo que vive en sus barcos en las zonas costeras del sudeste asiático (ver imagen). Se alimentan de organismos marinos, y su especialidad es bucear, hasta una profundidad de setenta metros y durante muchos minutos, para recolectar pepinos de mar y otros animales que se venden hasta a restaurantes de Hong Kong. Sus cuerpos se han adaptado a este estilo de vida: tienen el bazo, un órgano en el abdomen que – entre otras cosas – filtra la sangre y almacena glóbulos rojos, un 50% más grande que los pueblos en la región que no bucean. La ventaja de un bazo grande estriba en que este se encoge cuando el individuo se encuentra sumergido sin poder respirar, inyectando en los vasos sanguíneos una gran cantidad de glóbulos rojos cargados de oxígeno. Esta adaptación es genética: la tienen prácticamente todos los bajau, independientemente de si bucean o no [27].
Un cambio que ocurrió antes, hace tal vez unos millones de años, es el que permite a los humanos correr durante largos períodos, sin sobrecalentarse – algo de que otros animales, ni los más rápidos, son capaces. Esta capacidad probablemente ayudó nuestros ancestros sobrevivir en un mundo muy competitivo, al proporcionarles una ventaja a la hora de cazar animales: sencillamente los perseguían hasta que sus presas se cansaban. La base genética de la capacidad humana de realizar carreras de resistencia estriba, por lo menos en parte, en un defecto en el gen CMAH, que normalmente protege los músculos, pero, al ser defectuoso en los humanos, nos permite correr más tiempo sin que los músculos den señales de cansancio [28]. También se ajustó nuestro metabolismo a esas necesidades: nuestros cuerpos se adaptaron a utilizar, cazando animales o realizando otras labores, sólo pocas calorías más que cuerpos inactivos (lo que, por cierto, es una mala noticia para aquellas personas que desean perder peso haciendo ejercicio) [29].
Conclusión
Nuestra especie sigue siendo sometida a los vaivenes de la evolución. A pesar de todos los adelantos científicos, sigue habiendo muchas oportunidades para que la evolución pueda actuar. La exposición a enfermedades, por ejemplo, causa evolución – pero no sin matar a muchas personas, especialmente las más vulnerables tales como los más jóvenes y los más ancianos. Ayudaría si se pudiera vacunar a más gente contra las principales enfermedades (o si se dejaran vacunar) [30]. Pero, aun así, los humanos seguiremos estando expuestos a las fuerzas de la evolución. Justamente eso es lo que nos podría permitir evitar el destino que, tarde o temprano, espera a todas las especies: la extinción.
Nota: la foto en el encabezado de esta entrada muestra una mujer y niña quechuas en el Valle Sagrado de los Incas, Perú. Crédito: quinet. Fuente: https://commons.wikimedia.org/wiki/File:Quechuawomanandchild.jpg.
[1] Ver: www.scientificamerican.com/article/humans-are-doomed-to-go-extinct.
[2] Ver: http://es.wikipedia.org/wiki/Charles_Darwin.
[3] Darwin, Ch., 1859/1968. The origin of species by means of natural selection. Penguin Books, Londres.
[4] Darwin expone esto en los capítulos II a V de su Origin of species.
[5] Kostka, D., Hubisz, M.J., Siepel, A. y Pollard, K.S., 2012. The Role of GC-biased gene conversion in shaping the fastest evolving regions of the human genome. Molecular Biology and Evolution, 29 (3), 1047-1057. https://doi.org/10.1093/molbev/msr279.
[6] Ver: https://es.wikipedia.org/wiki/Deriva_gen%C3%A9tica.
[7] Guo, J. y otros, 2018. Global genetic differentiation of complex traits shaped by natural selection in humans. Nature Communications, 9, 1865. https://doi.org/10.1038/s41467-018-04191-y.
[8] Close, J.P., 2020. Ancient plagues shaped the world. Scientific American, noviembre 2020, 70-75. www.scientificamerican.com/article/solving-the-mysteries-of-ancient-plagues.
[9] Ver: https://es.wikipedia.org/wiki/Malaria.
[10] Hamid, I., Korunes, K.L., Beleza, S. y Goldberg, A., 2021. Rapid adaptation to malaria facilitated by admixture in the human population of Cabo Verde. eLife, 10, e63177. https://doi.org/10.7554/eLife.63177.
[11] Domínguez-Andrés, J. y Netea, M.G., 2019. Impact of historic migrations and evolutionary processes on human immunity. Trends in Immunology, 40 (12), 1105-1119. https://doi.org/10.1016/j.it.2019.10.001.
[12] Henneberg, M., Holloway-Kew, K. y Lucas T., 2021. Human major infections: Tuberculosis, treponematoses, leprosy—A paleopathological. perspective of their evolution. PLoS ONE, 16 (2), e0243687. https://doi.org/10.1371/journal.pone.0243687.
[13] Kerner, G., Laval, G., Patin, E., Boisson-Dupuis, S., Abel, L., Casanova, J.-L. y Quintana-Murci, L., 2021. Human ancient DNA analyses reveal the high burden of tuberculosis in Europeans over the last 2,000 years. The American Journal of Human Genetics, 108 (3), 517–524. https://doi.org/10.1016/j.ajhg.2021.02.009.
[14] Bailey, D.H. y Geary, D.C., 2009. Hominid Brain Evolution. Human Nature, 20, 67-79. https://doi.org/10.1007/s12110-008-9054-0.
[15] Ver: https://particle.scitech.org.au/people/we-are-still-evolving.
[16] Brutsaert, T.D. y otros, 2019. Association of EGLN1 gene with high aerobic capacity of Peruvian Quechua at high altitude. Proceedings of the National Academy of Sciences, 116 (48), 24006-24011. https://doi.org/10.1073/pnas.1906171116.
[17] Lorenzo, F.R. y otros, 2014. A genetic mechanism for Tibetan high-altitude adaptation. Nature Genetics, 46, 951-956. www.nature.com/articles/ng.3067.
[18] Lindo, J. y otros, 2018. The genetic prehistory of the Andean highlands 7000 years BP though European contact. Science Advances, 4 (11), eaau4921. https://doi.org/10.1126/sciadv.aau4921.
[19] Childebayeva, A., Goodrich, J.M., Leon-Velarde, F., Rivera-Chira, M., Kiyamu, M., Brutsaert, T.D., Dolinoy, D.C. y Bigham, A.W., 2021. Genome-wide epigenetic signatures of adaptive developmental plasticity in the Andes. Genome Biology and Evolution, 13 (2), evaa239. https://doi.org/10.1093/gbe/evaa239.
[20] Torres, J., Mahé, K., Dufour, J.L., Béarez, P. y San Román, M., 2020. Characterizing seasonal fishing patterns and growth dynamics during the Middle and Late Holocene in the Strait of Magellan (Chilean Patagonia): Sclerochronological analysis of tadpole codling (Salilota australis) vertebrae, The Journal of Island and Coastal Archaeology. https://doi.org/10.1080/15564894.2020.1755393.
[21] Aracena, C. y otros, 2015. Holocene variations in productivity associated with changes in glacier activity and freshwater flux in the central basin of the Strait of Magellan. Palaeogeography, Palaeoclimatology, Palaeoecology, 436, 112-122. https://doi.org/10.1016/j.palaeo.2015.06.023.
[22] Wilkin, S. y otros, 2021. Dairying enabled Early Bronze Age Yamnaya steppe expansions. Nature. https://doi.org/10.1038/s41586-021-03798-4.
[23] Burger, J. y otros, 2020. Low prevalence of lactase persistence in Bronze Age Europe indicates ongoing strong selection over the last 3,000 years. Current Biology, 30, 1-9. https://doi.org/10.1016/j.cub.2020.08.033.
[24] Ranciaro, A. y otros, 2014. Genetic origins of lactase persistence and the spread of pastoralism in Africa. American Journal of Human Genetics, 94, 496-510. www.sciencedirect.com/science/article/pii/S0002929714000676. Tishkoff, S.A. y otros, 2006. Convergent adaptation of human lactase persistence in Africa and Europe. Nature Genetics, 39, 31-40. www.nature.com/ng/journal/v39/n1/abs/ng1946.html.
[25] Ungar, P.S., 2020. The trouble with teeth. Scientific American, abril 2020, 45-49. www.scientificamerican.com/article/why-we-have-so-many-problems-with-our-teeth.
[26] Cox, S.L., Ruff, C.B., Maier, R.M. y Mathieson, I., 2019. Genetic contributions to variation in human stature in prehistoric Europe. Proceedings of the National Academy of Sciences, 116 (43), 21484-21492. https://doi.org/10.1073/pnas.1910606116.
[27] Ilardo, M.A. y otros, 2018. Physiological and genetic adaptations to diving in Sea Nomads. Cell, 173, 569–580. https://doi.org/10.1016/j.cell.2018.03.054. Ver también: https://elpais.com/elpais/2018/04/19/ciencia/1524146166_193774.html#.
[28] Okerblom, J., Fletes, W., Patel, H.H., Schenk, S., Varki, A. y Breen, E.C., 2018 Human-like Cmah inactivation in mice increases running endurance and decreases muscle fatigability: implications for human evolution. Proceedings of the Royal Society of London B, 285, 20181656. http://doi.org/10.1098/rspb.2018.1656.
[29] Pontzer, H., 2017. The exercise paradox. Scientific American, febrero 2017, 22-27. www.scientificamerican.com/article/the-exercise-paradox.
[30] Ver: https://theconversation.com/its-time-we-stopped-human-evolution-geneticist-116544; https://phys.org/news/2019-05-human-evolution-geneticist.html.